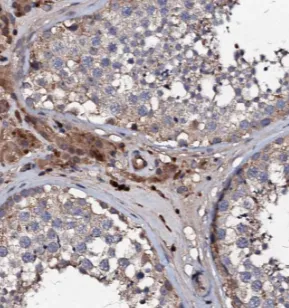
EXD1 antibody - image 1

EXD1 antibody
CAT:
710-FNab02889
Size:
100 µg
Price:
Ask
- Availability: 24/48H Stock Items & 2 to 6 Weeks non Stock Items.
- Dry Ice Shipment: No

EXD1 antibody
Background:
RNA-binding component of the PET complex, a multiprotein complex required for the processing of piRNAs during spermatogenesis. The piRNA metabolic process mediates the repression of transposable elements during meiosis by forming complexes composed of piRNAs and Piwi proteins and governs the methylation and subsequent repression of transposable elements, preventing their mobilization, which is essential for the germline integrity(By similarity). The PET complex is required during the secondary piRNAs metabolic process for the PIWIL2 slicing-triggered loading of PIWIL4 piRNAs. In the PET complex, EXD1 probably acts as an RNA adapter. EXD1 is an inactive exonuclease(By similarity).Synonyms:
piRNA biogenesis protein EXD1|Exonuclease 3'-5' domain-containing protein 1|Exonuclease 3'-5' domain-like-containing protein 1|Inactive exonuclease EXD1|EXD1|EXDL1Gene ID:
161829UniProt:
Q8NHP7Host:
RabbitReactivity:
Human, Mouse, RatImmunogen:
exonuclease 3'-5' domain containing 1Target:
EXD1Clonality:
PolyclonalIsotype:
IgGApplications:
ELISA, WB, IHC, IFField of Research:
MetabolismPurification:
Immunogen affinity purifiedDilution:
WB: 1:200-1:1000; IHC: 1:50-1:500; IF: 1:20-1:200Purity:
≥95% as determined by SDS-PAGEForm:
LiquidMolecular Weight:
36 kDaStorage Conditions:
PBS with 0.02% sodium azide and 50% glycerol pH 7.3, -20°C for 12 months(Avoid repeated freeze / thaw cycles.)CAS Number:
9007-83-4